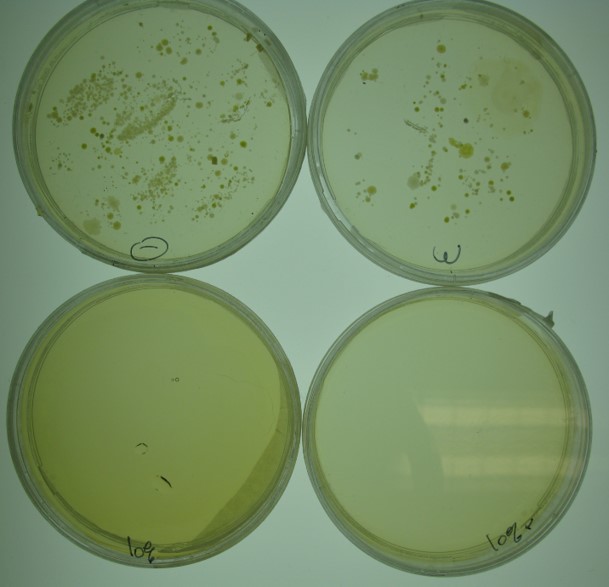
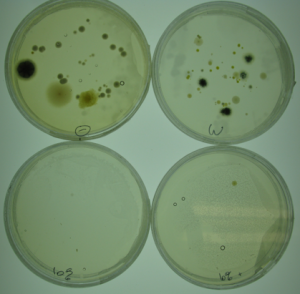
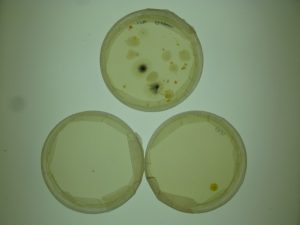

L-Care can be applied in many environments safely via :

Lab report on the efficiency of ‘L-care’ in cleaning hands and office room from harmful micro-organisms by use of a small sized sterilizer
Drs. Ing. Raphael Kiekens, Vrije Universiteit Brussel, Pleinlaan 2, 1050 Brussel
Human hands are a reservoir for potential harmful micro-organisms. This document describes the efficiency of the product ‘L-care’ from Limit Group (nv Aalst). In a first experiment we test the efficiency of cleaning the hands from bacteria and fungi with the aid of a small sized sterilizer. We report 100% cleaning of the hands from bacteria and fungi after short exposure to humidified 10% (v/v in water) L-care. In a second experiment we test the efficiency of the same small sized sterilizer with 10% (v/v in water) L-care on killing contaminants from the air in a common office room. We see a drastic reduction of potential harmful bacteria or fungi from the air up to 100% after 1h and even 24h after the treatment of the room. For all experiments, no accumulation of gaseous ClO2 was detected during or after the humidification process.
Material and Methods
L-care (2.5%, Limit Group nv Aalst) in ddH2O 10% (v/v), total volume used in sterilizer is 50 ml;
NAM (Nutrient Agar Medium) consisting of 0.5% peptone, 0.3% beef extract, 1.5% agar, 0.5% NaCl, pH 7.2 in demi-water for measuring bacterial contamination (37°C incubator);
SAM (Sabouraud Agar Medium) consisting of 4% dextrose, 1% peptone, 1.5% agar, pH 5.6, in demi-water for measuring fungal contamination (21°C incubator);
Experiment 1:
Control experiments: Before using the sterilizer we touched the NAM and SAM agar randomly with our fingers and sealed the plates afterwards; Sterilizer filled with tap water only. The small sterilizer was set on ‘auto’ and the whole left hand was in contact with the humidified water for 2 seconds. After 1 minute we touched the NAM and SAM plates randomly with our fingers and sealed the plates afterwards;
Treatments: Sterilizer filled with 10% (v/v) L-care (2,5%) in tap water. The small sterilizer was set on ‘auto’ and the whole left hand was in contact with the mist for 2 seconds. After 1 minute we touched the NAM and SAM plates randomly with our fingers and sealed the plates afterwards; Sterilizer filled with 10% (v/v) L-care (2,5%) + 75% ethanol in tap water. The small sterilizer was set on ‘auto’ and the whole right hand was in contact with the mist for 2 seconds;
Experiment 2 (small office room)
For the measurements each NAM and SAM plate was opened next to each other on a sterilized surface (cleaned with 70% ethanol) exposed to the air with 1m distance to the humidifier and other objects in each room. A 0h time point was obtained by opening the plates 1h before the start of the humidification. After 1h of humidification by setting the small sized sterilizer on ‘auto’ new SAM and NAM plates were placed on the same position and again exposed 1h to the air. After 24h two new SAM and NAM plates were put at the same places to measure the effect of the treatment after 24h. NAM plates for measuring the bacterial contamination in the air were grown in a 37°C incubator for 24h after counting the colony forming units (cfu’s), SAM plates for measuring the fungal contamination were grown at a 21°C incubator for 48h after counting the cfu’s. ClO2 gas (ppm) was measured at timepoint 0h, 1h and 24h after the humidification process.
BW™ Solo lite ClO2 gas detector (Charlotte, North Carolina, US);
Results and Discussion
Two experiments were performed: one to test the sterilizer to disinfect the hands and one experiment to test the disinfection of the air in a small office room.
For each experiment 10% (v/v) L-care or 10% (v/v) L-care + 75% ethanol (v/v) were used both by using the same sterilizer (Figure 1). Control experiments were done by using only pure water in the sterilizer and also without using the sanitizer at all. We see 100% reduction of the number of colony forming units (cfu’s) by use of 10% (v/v) L-care alone both for bacterial and fungal growth (Figure 2 and 3) on the hands. A bit surprisingly by use of 10% L-care + 75% ethanol, we found one cfu on the bacterial plate which can be explained by a very resistant fungi or a small external contamination during the experiment (Figure 2 and 3).

Figure 1 Small sized sterilizer producing a mist to sanitize the hands or to clean a small office room
Figure 1 Small sized sterilizer producing a mist to sanitize the hands or to clean a small office room
.
Figure 3 Results of the disinfection of fungal cells of the handpalms by using a small sized sterilizer using 10% L-care (C), 10% L-care + 75% ethanol (D). Controls are unsanitized hands (A) and sterilizer using only water (B).

Figure 4 Results of cleaning the air from bacterial cells in a small office room using 10% L-care for 1h with a measurement at A- 0h (control), B- 1h and C- 24h after the treatment.
For the second experiment a small office room was used in which we nebulized the room for 1h with the small sterilizer set on ‘auto’ containing 10% (v/v) L-care. We first did a 0h control time point, before the L-care treatment, in which both NAM and SAM plates are exposed 1h to the air and sealed after this hour. Then the humidifier, filled with 10% (v/v) L-care is timed to 1h. New NAM and SAM plates are subsequently placed in the same positions as the 0h control time point plates and also exposed 1h to the air after which they are sealed. We repeat the last step but at 24h after the room treatment. All plates were incubated at the appropriate temperatures and times. We see a total reduction of cfu’s after 1h of treatment and up to 95% at 24h after the treatment (Figure 4-5).
Importantly no ClO2 gas was detected before, during or after each humidification process (Figure 6).

Figure 6 No ClO2 (0 ppm)
was detected before, during or after each humidification procedure

Figure 5 Results of cleaning the air from fungal cells in a small office room using 10% L-care for 1h with a measurement at A- 0h (control), B- 1h and C- 24h after the treatment.
In conclusion these results show a complete or 100% reduction of potential harmful bacteria and fungi on the hands by using a 10% (v/v) L-care solution in a small sized hand sanitizer after 2 seconds of contact with the mist. The addition of 75% ethanol to the mixture is optional. In addition the small sized sterilizer can clean the room from potentially harmful bacteria and fungi after 1h of treatment with an effect up to 24h up to 100%.
When can L-Carelose its efficiency?
-When activated due to contact with lowered PH substances or organism
-When exposed to UV light due to the use of translucent containers
-When exposed to temperatures above 35-40Cº
-After Bacterial contact but proportional to the amount of exposure.
When can L-Carelose its efficiency?
-When activated due to contact with lowered PH substances or organism
-When exposed to UV light due to the use of translucent containers
-When exposed to temperatures above 35-40Cº
-After Bacterial contact but proportional to the amount of exposure.
How can it be prevented?
-The use of a sealed opaque bottle or crate to prevent UV ray contact
-Use isolating materials when needed to prevent overheating
-Use of product stabilizer
How can we control this?
-Odor: L-Care is practically odorless but when activated chloride smell comes free
-Sedimentation: presence of sedimentation indicates partial or total activation
-Color: Applying citric acid to L-Care in an assay tube will reveal a color change from transparent white to yellow. A yellow spectrum range may be used to measure quality grade.
Types of analysis of L-Care:
– Behavior of L-Care when deactivated / activated
-L-Care before activation is practically odorless Active 7 days.
-L-Care after activation clear chloride smell and becomes yellow in color.
Laboratory:
-L-Care before activation will reveal no more than ± 1% Chloride radicals and some mineral presence.
-L-Care after activation increases the % of free chloride presence.
.